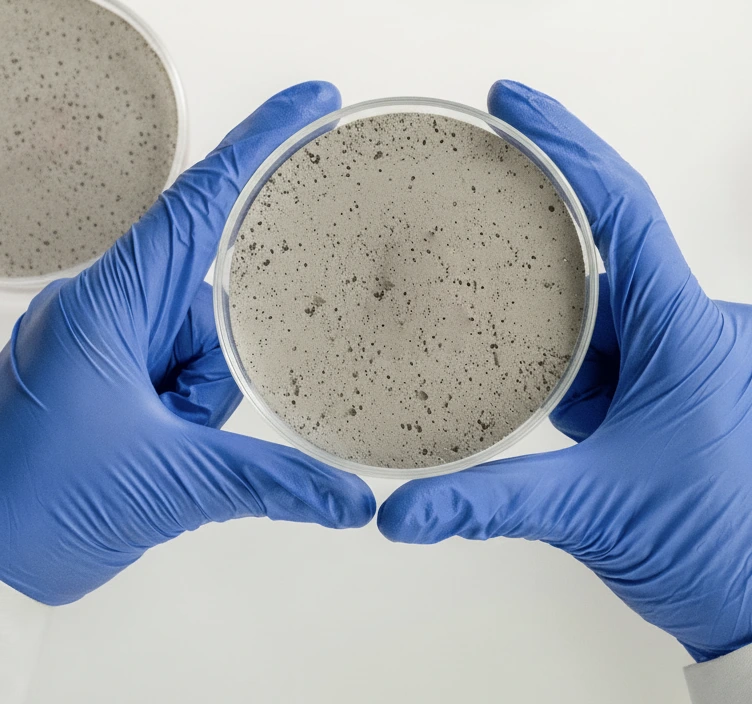

Диоксид кремния выполняет роль не просто добавки, а модификатора структуры. Он запускает пуццолановую реакцию, превращая побочные продукты гидратации в полезный конструкционный камень, и работает как микронаполнитель, физически заполняя пустоты между зернами цемента.

Ключевым фактором реакционной способности в щелочной среде бетона является аморфное (некристаллическое) состояние вещества. Кристаллический кварц такой активностью не обладает.
В процессе гидратации цемента образуется портландит (Ca(OH)₂) – "слабое звено" бетона, склонное к вымыванию. Активный диоксид кремния связывает Ca(OH)₂, превращая его в прочный гидросиликат кальция.

Кремнеземный функциональный наполнитель для бетона критически важен там, где требуются экстремальные эксплуатационные характеристики. Это высокопрочные бетоны (класса B60 и выше), гидроизоляционные растворы и торкрет-бетон.

Введение активного SiO₂ блокирует капиллярные поры, трансформируя структуру строительного материала. Бетон становится практически водонепроницаемым, что критически повышает его эксплуатационный ресурс.

Важным отличием синтетического порошкового кремнезема является его чистота.


Завод "РусСилика" вывел на строительный рынок порошковый кремнезем RUSGEL – высокоактивный пуццолановый компонент нового поколения. Это надежное решение для производителей, столкнувшихся с проблемой нестабильного качества готовой продукции или высокой стоимостью импортных метакаолинов и нанокремнезема.
RUSGEL разработан в строгом соответствии с требованиями производителей сухих строительных смесей (ССС) и товарного бетона. Мы гарантируем стабильность физико-химических характеристик от партии к партии, что является фундаментом для прогнозируемого качества вашего продукта.

RUSGEL – это продукт, технические параметры которого адаптированы специально для решения сложных строительных задач. Каждая характеристика играет свою роль в формировании целевой структуры бетона.
Технические параметры и их значение:
Совокупность этих свойств делает RUSGEL мощным инструментом в руках технолога, позволяя проектировать составы с заранее заданными, высокими эксплуатационными свойствами.
Технологи ведущих предприятий выбирают RUSGEL как альтернативу традиционным добавкам. Переход на синтетический продукт открывает новые возможности для оптимизации производства и улучшения качества продукции.
Ключевые выгоды для производства:
Выбирая RUSGEL, вы инвестируете в предсказуемость производственного процесса и безупречное качество готовых изделий. Начните использовать современные материалы уже сегодня.
Производственный комплекс "РусСилика" спроектирован с учетом современных принципов устойчивого развития. В основе производства лежат энергоэффективные технологии синтеза, которые существенно минимизируют углеродный след.
RUSGEL полностью безопасен для окружающей среды и человека, что подтверждено соответствующими сертификатами. Это открывает возможности для его использования в жилищном строительстве, при возведении резервуаров для питьевой воды и объектов здравоохранения.
Мы предлагаем гибкие условия сотрудничества для заводов ЖБИ, производителей товарного бетона и сухих смесей. Логистика отстроена для оперативной поставки как промышленных объемов в биг-бегах, так и партий под специальные проекты.
Чтобы убедиться в эффективности материала, вы можете заказать тестовые образцы для лабораторных испытаний. Наши технологи помогут с расчетом рецептуры и интеграцией добавки в ваш производственный цикл. Свяжитесь с нами для получения коммерческого предложения.








© 2020-2024 ООО "РусСилика" ОГРН 1205500027710, ИНН 5501267734, КПП 660850001.
Вся информация на сайте носит справочный характер и не является публичной офертой, определяемой статьей 437 ГК РФ.